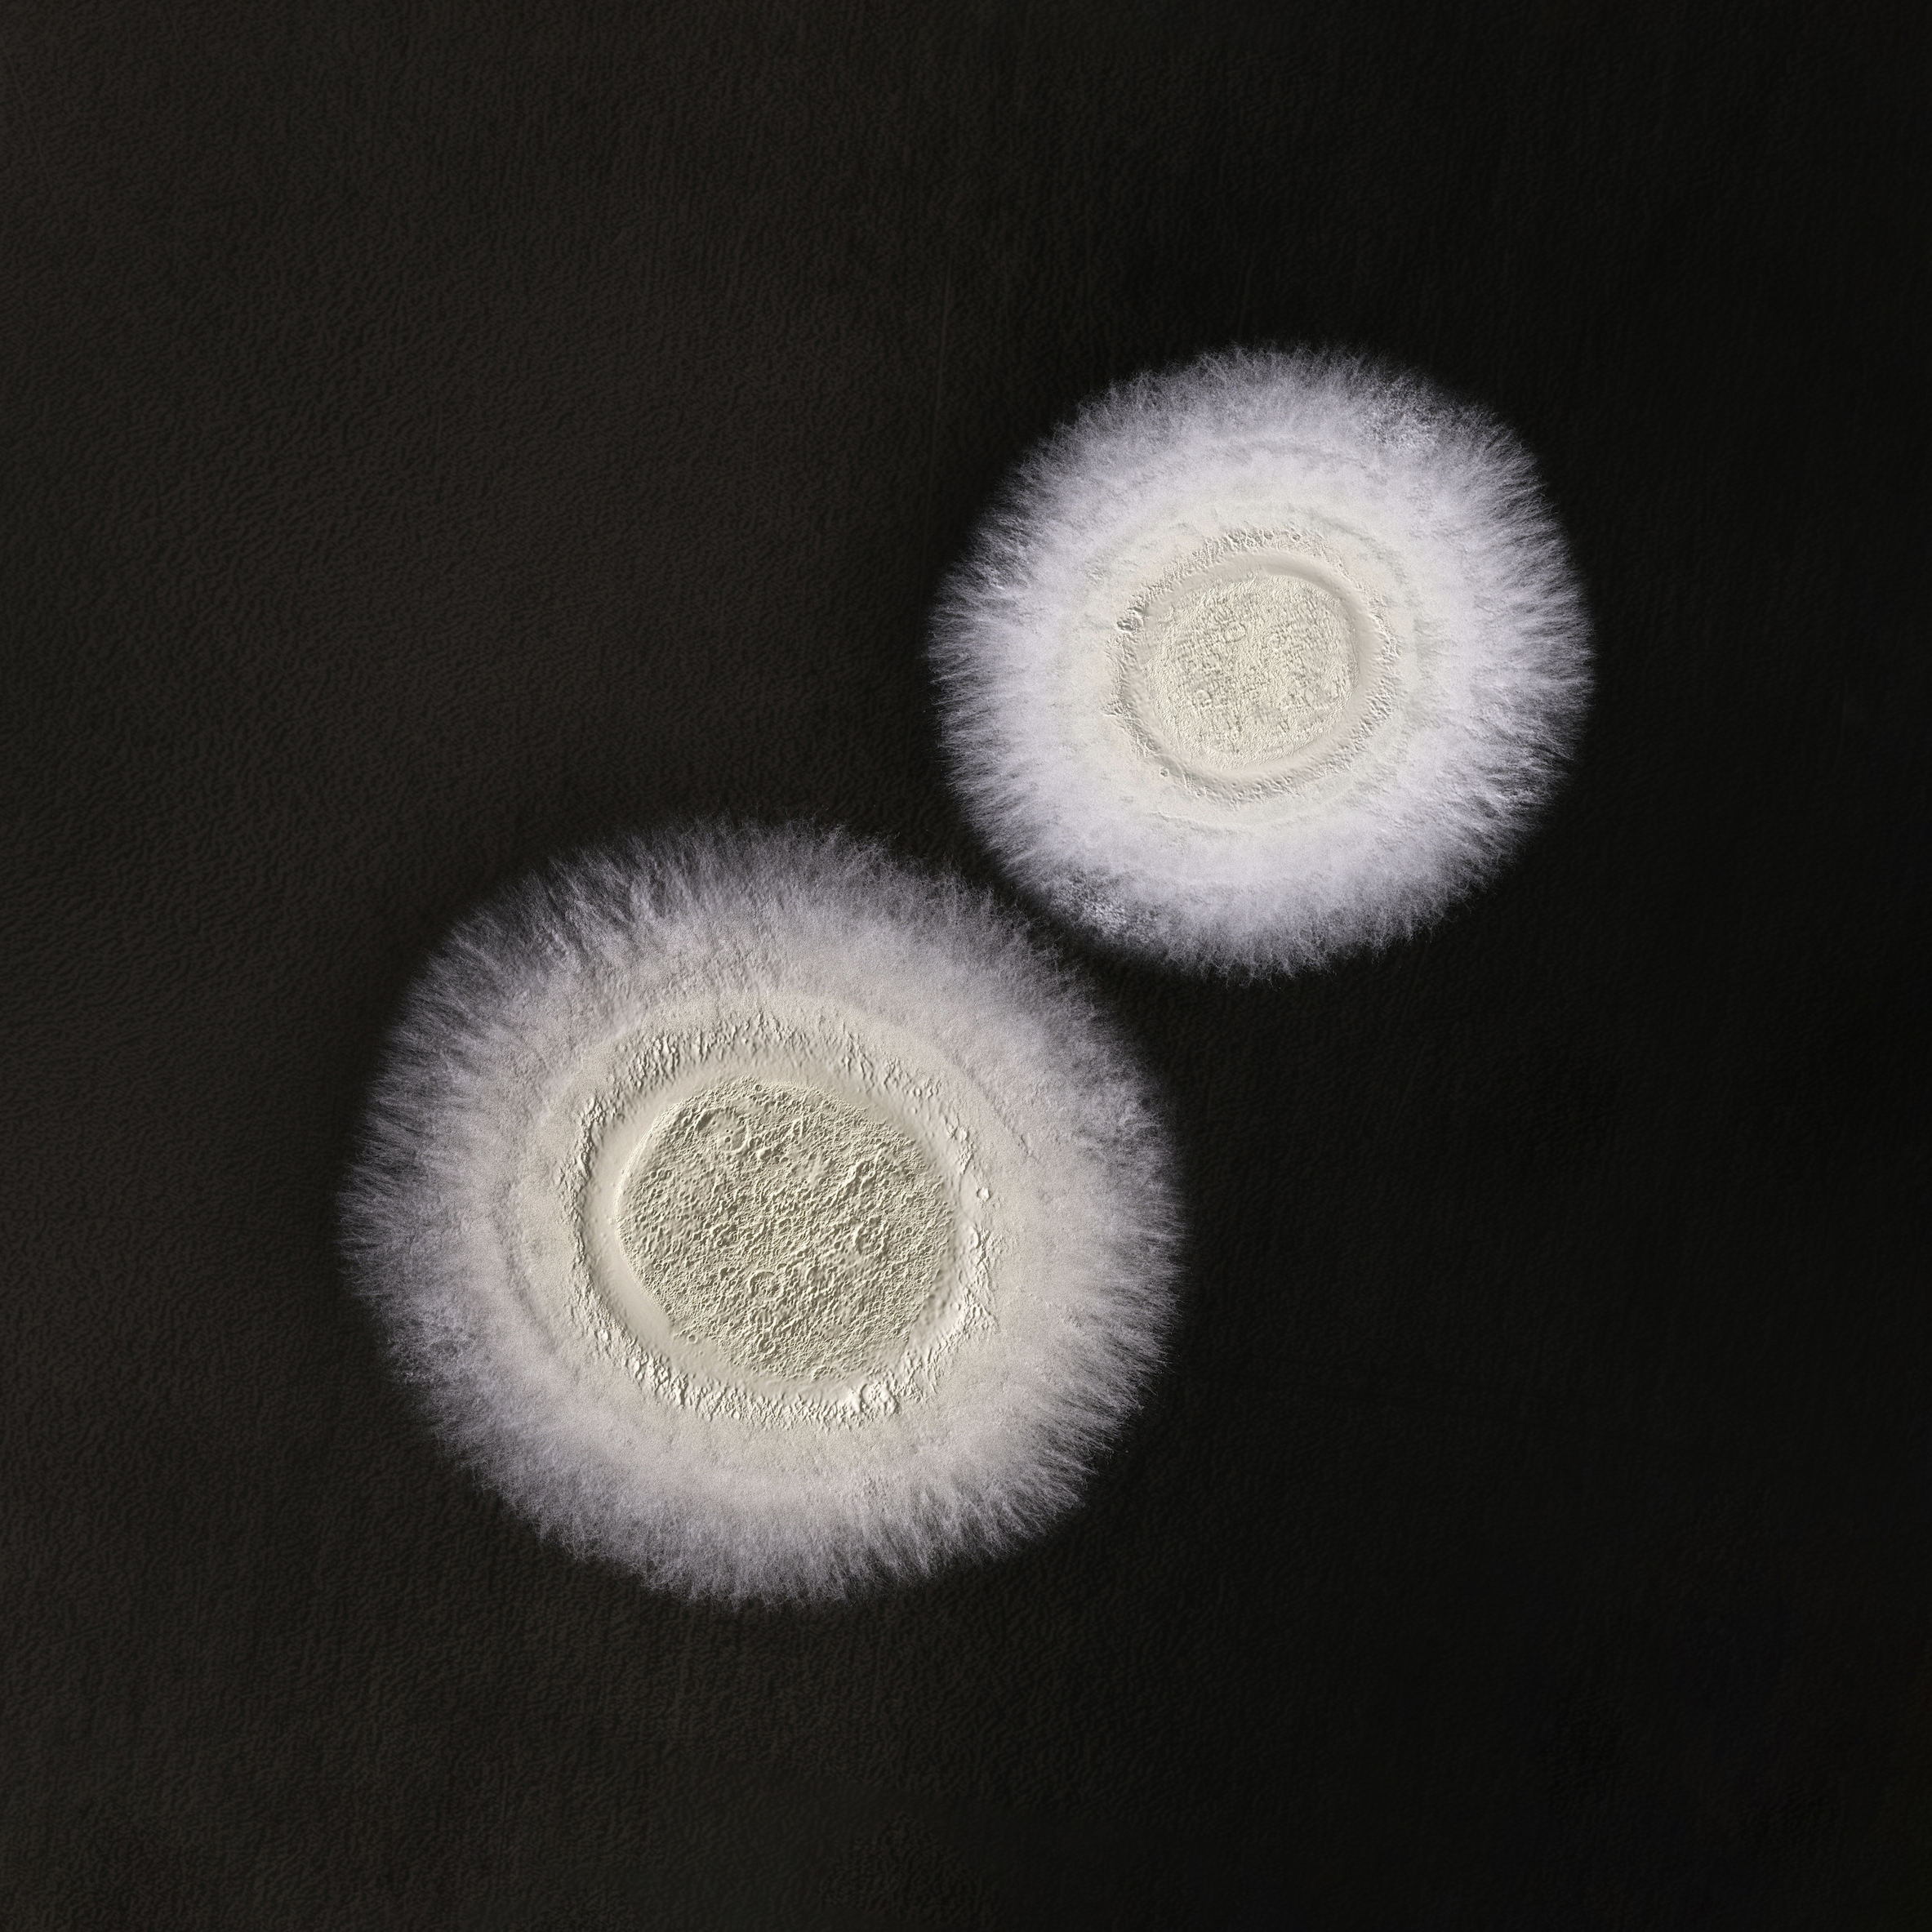
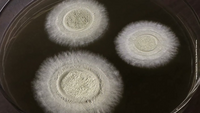

Utilizar para
Cultivos
Extensivos, hortalizas, frutales y tabaco.
Se aplican las condiciones generales de Koppert (Koppert B.V. y/o sus empresas afiliadas). Solo
se deben usar productos autorizados en su país o estado y cultivo. Cumpla en todo momento con la
obligación de registro local. Koppert no se responsabiliza del uso no autorizado del producto.
Koppert no se responsabiliza de la pérdida de calidad, si el producto se almacena durante más tiempo
del recomendado o bajo condiciones no apropiadas.